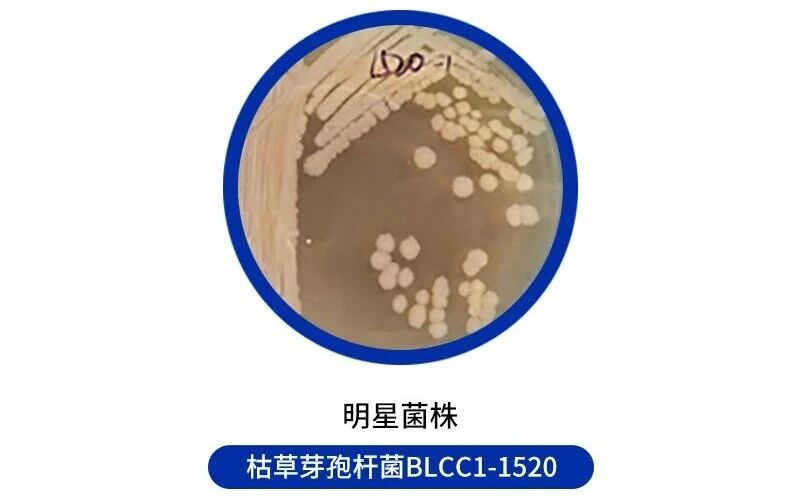
969c6e73296faf72003838e26c983dbd.jpg

在畜牧养殖朝着绿色无抗方向转型的今天,益生菌菌株的筛选与应用成为提升养殖效益、保障动物健康的关键。今天,我们聚焦一株源自西伯利亚永久冻土环境的“明星菌株”——枯草芽孢杆菌BLCC1-1520(保藏编号:CCTCC NO:M 20241938),深度解析其核心益生价值与全场景应用潜力。
当前,绿色无抗养殖已成为畜牧行业高质量发展的必然趋势,益生菌作为替代抗生素的核心方案,其菌株性能是影响养殖效益的关键因素之一。枯草芽孢杆菌BLCC1-1520由宝来利来从西伯利亚永久冻土中筛选培育,历经极端环境淬炼,具备耐酸、耐胆盐、低温适应强等独特优势:在pH=2-2.5的极端酸性环境中仍保持7.5%-33.3%的存活率,0.5%高胆盐环境下存活率接近50%,可顺利穿越动物消化道屏障;10℃低温环境下生长能力显著优于普通菌株,适配寒冷地区养殖需求。经试验验证,该菌株遗传稳定性优异,产酶与益生性能稳定可靠,不仅完美适配无抗养殖核心需求,更成为推动行业转型的关键菌株。
表1 耐酸性试验结果

表2 胆盐耐受性试验结果

表3 不同培养温度OD600值

表4 产酶性能

动物机体代谢过程中,过量产生自由基会引发氧化损伤,影响生长性能和健康状态。枯草芽孢杆菌BLCC1-1520通过精准调节机体抗氧化系统,有效增强抗氧化能力:
- 提升核心抗氧化指标活性:可显著提升动物血清总抗氧化能力和超氧化物歧化酶活性,为抗氧化提供核心动力。
- 减少氧化损伤产物:有效降低脂质过氧化产物含量,减少自由基对细胞的攻击,保护细胞膜完整性,为动物机体构建第一道抗氧化防线。
肠道屏障是动物抵御外界病原体入侵、保障营养吸收的核心防线,其功能完整性直接关联机体健康。该菌从两方面改善肠道屏障功能:
● 加固物理屏障:显著提升肠道黏膜紧密连接蛋白的表达水平,增强肠道黏膜紧密性,减少有害物质和病原菌穿透;同时促进肠道形态发育,扩大营养吸收表面积。
● 优化免疫屏障:提升肠道黏膜分泌型免疫球蛋白A含量,增强肠道局部抗感染能力;降低促炎因子水平,抑制炎症反应,维护肠道内环境稳定。

图:肠道黏膜的四大屏障及其相互作用机制
免疫功能的强弱直接决定动物对疾病的抵抗力,枯草芽孢杆菌BLCC1-1520通过多维度调控,从多方面提升动物免疫功能,具体机制如下:
显著提升核心免疫器官指数,为淋巴细胞的生成与成熟提供良好环境,夯实体液免疫基础。
可显著提升动物抗体效价,且能长期维持较高抗体水平。
调节免疫球蛋白水平,全方位增强机体对病原体的识别与清除能力。
养殖过程中的寒冷、高温、运输等应激因素,会导致动物体内氧化应激反应加剧,进而影响生长。该菌具备优异的抗氧化应激能力,可针对性缓解不同类型应激损伤:
精准抵御冷应激:有效降低冷应激导致的动物死亡风险,提升寒冷环境下的养殖存活率。
有效缓解热应激:改善高温环境下动物的生长状态,降低料肉比、提升生长速度,保障热应激场景下的养殖效益。
核心调控机制:通过强化机体抗氧化系统,快速清除应激状态下产生的过量自由基,抑制氧化应激信号通路的激活,稳定机体代谢与生理功能,保障应激条件下的生产性能。
肠道致病菌滋生与过度炎症反应是养殖中常见的肠道健康问题,本菌兼具抗菌与抗炎双重作用,有助于解决这一痛点:
强效抑制致病菌:通过分泌抗菌活性物质,对多种常见肠道致病菌产生显著抑制作用;同时竞争肠道营养与空间,进一步抑制有害菌增殖,维护肠道菌群平衡。
精准调节炎症平衡:通过调节细胞因子网络实现抗炎效果,显著提升抗炎因子水平,降低促炎因子含量,抑制过度炎症反应,减少炎症对肠道黏膜的损伤,维护肠道微生态稳定。
绿色养殖的核心需求是实现动物高效生长,枯草芽孢杆菌BLCC1-1520通过“营养转化优化+机体健康保障”的协同作用,显著促进动物生长:
具备优异的产酶性能,分泌多种高活性消化酶,可有效分解饲料中的蛋白质、粗纤维、淀粉等营养成分,提升饲料消化吸收效率。
通过改善肠道健康、增强免疫力、抵御应激等作用,减少动物生长过程中的健康损耗,让生长潜力充分释放。
优化动物生长性能,改善屠宰品质,直接提升养殖经济效益。
枯草芽孢杆菌BLCC1-1520经多场景实证,效果显著,具体数据如下:
料肉比降低10%左右,日均增重90.12g,屠宰率提高2.40%;冬季雏鸡冷应激场景下存活率高达97.78%;42日龄免疫器官指数提升20.37%,抗炎因子IL-4提升64.78%、IL-10提升34.24%,总肠道长度增加15.9%。
阳性不稳定猪场应用后,平均出栏率近80%。南方区域比对,12个使用该菌剂的养殖场无一清场,而对照组80余场中,发病清场率约34%。
在反刍动物养殖中,菌株能提高粗纤维消化率8%-12%,助力营养吸收优化;同时可提升产奶量5%-8%,直接提升养殖效益。
多场景试验表明,该菌株能精准解决不同养殖品类中饲料利用率低、肠道健康差、应激损伤等共性痛点,显著提升养殖经济效益。
作为无抗养殖浪潮中的明星菌株,枯草芽孢杆菌BLCC1-1520以六大核心作用为支撑,以多试验验证的应用效果为保障,为畜牧养殖行业提供了高效、温和、可持续的解决方案。未来,随着该菌株及系列产品的广泛推广应用,将进一步推动行业减少抗生素依赖,助力养殖企业实现降本增效,共同迈向绿色生态养殖的高质量发展新阶段!